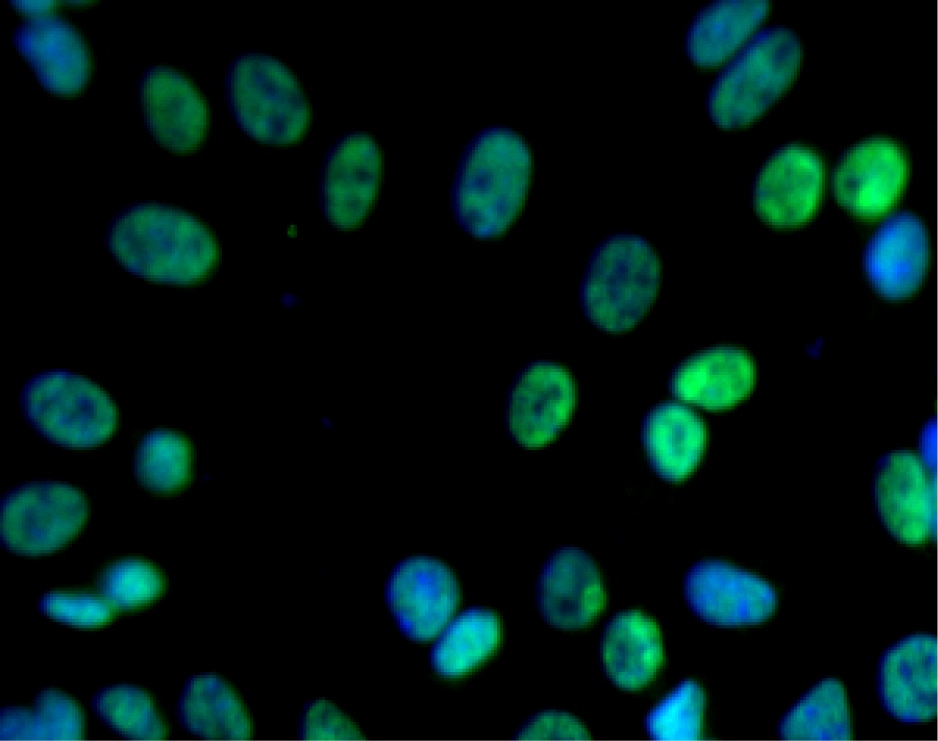
L10020_611714_image2_atto.png

-
Reagents
- Flow Cytometry Reagents
-
Western Blotting and Molecular Reagents
- Immunoassay Reagents
-
Single-Cell Multiomics Reagents
- BD® OMICS-Guard Sample Preservation Buffer
- BD® AbSeq Assay
- BD® OMICS-One Immune Profiler Protein Panel
- BD® Single-Cell Multiplexing Kit
- BD Rhapsody™ ATAC-Seq Assays
- BD Rhapsody™ Whole Transcriptome Analysis (WTA) Amplification Kit
- BD Rhapsody™ TCR/BCR Next Multiomic Assays
- BD Rhapsody™ Targeted mRNA Kits
- BD Rhapsody™ Accessory Kits
- BD® OMICS-One Protein Panels
-
Functional Assays
-
Microscopy and Imaging Reagents
-
Cell Preparation and Separation Reagents
-
Thought Leadership
- Product News
- Blogs
-
Scientific Publications
-
Events
- Expanding PARADIGM to Infectious Disease Modeling: HIV & Tuberculosis
- CYTO 2023: Advancing the World of Cytometry
- Advances in Immune Monitoring Series
- Validating Flow Cytometry Assays for Cell Therapy
- Enhancing Cell Analysis with a New Set of Eyes
- BD Biosciences at International Clinical Cytometry Society 2025
Old Browser
This page has been recently translated and is available in French now.
Looks like you're visiting us from {countryName}.
Would you like to stay on the current country site or be switched to your country?
BD Transduction Laboratories™ Purified Mouse Anti-Human LEDGF
Clone 26/LEDGF (RUO)

Western blot analysis of LEDGF on a HeLa cell lysate (Human cervical epitheloid carcinoma; ATCC CCL-2.2) (left). Lane 1: 1:1000, lane 2: 1:2000, lane 3: 1:4000 dilution of the mouse anti-human LEDGF antibody.
Immunofluorescent staining of SK-N-SH cells (Human neuroblastoma; ATCC HTB-11) (right). Cells were seeded in collagen coated 384-well imaging microplates (Material # 353962) at ~ 8,000 cells per well. After overnight incubation, cells were stained using the Triton-X 100 fix/perm protocol (see Recommended Assay Procedure) and the mouse anti-human LEDGF antibody. The second step reagent was Alexa Fluor® 488 goat anti mouse Ig (Invitrogen) (pseudo-colored green) and counter-stained with Hoechst 33342 (pseudo-colored blue). The images were captured on a BD Pathway™ 855 or 435 Bioimager system using a 20x objective and merged using BD Attovision™ software. This antibody also stained SH-SY5Y (Human neuroblastoma; ATCC CRL-2266), C6 (Rat glioma; ATCC CCL-107), U-87 MG (Human glioblastoma cells; ATCC HTB-14) and U-373 cells (Human glioblastoma cells; ATCC HTB-17; discontinued, investigators may refer to: http://www.atcc.org/MisidentifiedCellLines/tabid/683/Default.aspx ) using both the Triton-X 100 and methanol fix/perm protocols (see Recommended Assay Procedure).

Western blot analysis of LEDGF on a HeLa cell lysate (Human cervical epitheloid carcinoma; ATCC CCL-2.2) (left). Lane 1: 1:1000, lane 2: 1:2000, lane 3: 1:4000 dilution of the mouse anti-human LEDGF antibody.
Immunofluorescent staining of SK-N-SH cells (Human neuroblastoma; ATCC HTB-11) (right). Cells were seeded in collagen coated 384-well imaging microplates (Material # 353962) at ~ 8,000 cells per well. After overnight incubation, cells were stained using the Triton-X 100 fix/perm protocol (see Recommended Assay Procedure) and the mouse anti-human LEDGF antibody. The second step reagent was Alexa Fluor® 488 goat anti mouse Ig (Invitrogen) (pseudo-colored green) and counter-stained with Hoechst 33342 (pseudo-colored blue). The images were captured on a BD Pathway™ 855 or 435 Bioimager system using a 20x objective and merged using BD Attovision™ software. This antibody also stained SH-SY5Y (Human neuroblastoma; ATCC CRL-2266), C6 (Rat glioma; ATCC CCL-107), U-87 MG (Human glioblastoma cells; ATCC HTB-14) and U-373 cells (Human glioblastoma cells; ATCC HTB-17; discontinued, investigators may refer to: http://www.atcc.org/MisidentifiedCellLines/tabid/683/Default.aspx ) using both the Triton-X 100 and methanol fix/perm protocols (see Recommended Assay Procedure).



Western blot analysis of LEDGF on a HeLa cell lysate (Human cervical epitheloid carcinoma; ATCC CCL-2.2) (left). Lane 1: 1:1000, lane 2: 1:2000, lane 3: 1:4000 dilution of the mouse anti-human LEDGF antibody.
Immunofluorescent staining of SK-N-SH cells (Human neuroblastoma; ATCC HTB-11) (right). Cells were seeded in collagen coated 384-well imaging microplates (Material # 353962) at ~ 8,000 cells per well. After overnight incubation, cells were stained using the Triton-X 100 fix/perm protocol (see Recommended Assay Procedure) and the mouse anti-human LEDGF antibody. The second step reagent was Alexa Fluor® 488 goat anti mouse Ig (Invitrogen) (pseudo-colored green) and counter-stained with Hoechst 33342 (pseudo-colored blue). The images were captured on a BD Pathway™ 855 or 435 Bioimager system using a 20x objective and merged using BD Attovision™ software. This antibody also stained SH-SY5Y (Human neuroblastoma; ATCC CRL-2266), C6 (Rat glioma; ATCC CCL-107), U-87 MG (Human glioblastoma cells; ATCC HTB-14) and U-373 cells (Human glioblastoma cells; ATCC HTB-17; discontinued, investigators may refer to: http://www.atcc.org/MisidentifiedCellLines/tabid/683/Default.aspx ) using both the Triton-X 100 and methanol fix/perm protocols (see Recommended Assay Procedure).
Western blot analysis of LEDGF on a HeLa cell lysate (Human cervical epitheloid carcinoma; ATCC CCL-2.2) (left). Lane 1: 1:1000, lane 2: 1:2000, lane 3: 1:4000 dilution of the mouse anti-human LEDGF antibody.
Immunofluorescent staining of SK-N-SH cells (Human neuroblastoma; ATCC HTB-11) (right). Cells were seeded in collagen coated 384-well imaging microplates (Material # 353962) at ~ 8,000 cells per well. After overnight incubation, cells were stained using the Triton-X 100 fix/perm protocol (see Recommended Assay Procedure) and the mouse anti-human LEDGF antibody. The second step reagent was Alexa Fluor® 488 goat anti mouse Ig (Invitrogen) (pseudo-colored green) and counter-stained with Hoechst 33342 (pseudo-colored blue). The images were captured on a BD Pathway™ 855 or 435 Bioimager system using a 20x objective and merged using BD Attovision™ software. This antibody also stained SH-SY5Y (Human neuroblastoma; ATCC CRL-2266), C6 (Rat glioma; ATCC CCL-107), U-87 MG (Human glioblastoma cells; ATCC HTB-14) and U-373 cells (Human glioblastoma cells; ATCC HTB-17; discontinued, investigators may refer to: http://www.atcc.org/MisidentifiedCellLines/tabid/683/Default.aspx ) using both the Triton-X 100 and methanol fix/perm protocols (see Recommended Assay Procedure).

Western blot analysis of LEDGF on a HeLa cell lysate (Human cervical epitheloid carcinoma; ATCC CCL-2.2) (left). Lane 1: 1:1000, lane 2: 1:2000, lane 3: 1:4000 dilution of the mouse anti-human LEDGF antibody.
Immunofluorescent staining of SK-N-SH cells (Human neuroblastoma; ATCC HTB-11) (right). Cells were seeded in collagen coated 384-well imaging microplates (Material # 353962) at ~ 8,000 cells per well. After overnight incubation, cells were stained using the Triton-X 100 fix/perm protocol (see Recommended Assay Procedure) and the mouse anti-human LEDGF antibody. The second step reagent was Alexa Fluor® 488 goat anti mouse Ig (Invitrogen) (pseudo-colored green) and counter-stained with Hoechst 33342 (pseudo-colored blue). The images were captured on a BD Pathway™ 855 or 435 Bioimager system using a 20x objective and merged using BD Attovision™ software. This antibody also stained SH-SY5Y (Human neuroblastoma; ATCC CRL-2266), C6 (Rat glioma; ATCC CCL-107), U-87 MG (Human glioblastoma cells; ATCC HTB-14) and U-373 cells (Human glioblastoma cells; ATCC HTB-17; discontinued, investigators may refer to: http://www.atcc.org/MisidentifiedCellLines/tabid/683/Default.aspx ) using both the Triton-X 100 and methanol fix/perm protocols (see Recommended Assay Procedure).

Western blot analysis of LEDGF on a HeLa cell lysate (Human cervical epitheloid carcinoma; ATCC CCL-2.2) (left). Lane 1: 1:1000, lane 2: 1:2000, lane 3: 1:4000 dilution of the mouse anti-human LEDGF antibody.
Immunofluorescent staining of SK-N-SH cells (Human neuroblastoma; ATCC HTB-11) (right). Cells were seeded in collagen coated 384-well imaging microplates (Material # 353962) at ~ 8,000 cells per well. After overnight incubation, cells were stained using the Triton-X 100 fix/perm protocol (see Recommended Assay Procedure) and the mouse anti-human LEDGF antibody. The second step reagent was Alexa Fluor® 488 goat anti mouse Ig (Invitrogen) (pseudo-colored green) and counter-stained with Hoechst 33342 (pseudo-colored blue). The images were captured on a BD Pathway™ 855 or 435 Bioimager system using a 20x objective and merged using BD Attovision™ software. This antibody also stained SH-SY5Y (Human neuroblastoma; ATCC CRL-2266), C6 (Rat glioma; ATCC CCL-107), U-87 MG (Human glioblastoma cells; ATCC HTB-14) and U-373 cells (Human glioblastoma cells; ATCC HTB-17; discontinued, investigators may refer to: http://www.atcc.org/MisidentifiedCellLines/tabid/683/Default.aspx ) using both the Triton-X 100 and methanol fix/perm protocols (see Recommended Assay Procedure).

Regulatory Status Legend
Any use of products other than the permitted use without the express written authorization of Becton, Dickinson and Company is strictly prohibited.
Preparation And Storage
Recommended Assay Procedures
Western blot: Please refer to http://www.bdbiosciences.com/pharmingen/protocols/Western_Blotting.shtml
Bioimaging:
Methanol Procedure for a 96 well plate:
Remove media from wells. Add 100 µl/well fresh 3.7% Formaldehyde in PBS. Incubate for 10 minutes at room temperature (RT). Flick out and add 100 µl/well 90% methanol. Incubate for 5 minutes at RT. Flick out and wash twice with PBS. Flick out PBS and add 100 µl/well blocking buffer (3% FBS in PBS). Incubate for 30 minutes at RT. Flick out and add diluted antibody (diluted in blocking buffer). Incubate for 1 hour at RT. Wash three times with PBS. Flick out PBS and add second step reagent. Incubate for 1 hour at RT. Wash three times with PBS. Image sample.
Triton-X 100 Procedure for a 96 well plate:
Remove media from wells. Add 100 µl/well fresh 3.7% Formaldehyde in PBS. Incubate for 10 minutes at room temperature (RT). Flick out and add 100 µl/well 0.1% Triton-X 100. Incubate for 5 minutes at RT. Flick out and wash twice with PBS. Flick out PBS and add 100 µl/well blocking buffer (3% FBS in PBS). Incubate for 30 minutes at RT. Flick out and add diluted antibody (diluted in blocking buffer). Incubate for 1 hour at RT. Flick out and wash three times with PBS. Flick out and add second step reagent. Incubate for 1 hour at RT. Flick out and wash three times with PBS. Image sample.
Product Notices
- Since applications vary, each investigator should titrate the reagent to obtain optimal results.
- Please refer to www.bdbiosciences.com/us/s/resources for technical protocols.
- Caution: Sodium azide yields highly toxic hydrazoic acid under acidic conditions. Dilute azide compounds in running water before discarding to avoid accumulation of potentially explosive deposits in plumbing.
- Source of all serum proteins is from USDA inspected abattoirs located in the United States.
Companion Products


p52/p75 proteins were first identified through their interaction with transcriptional factors and splicing factors. p75 is encoded by exons 1-15 and contains 530 amino acids, while the alternatively spliced p52 is encoded by exons 1-9 and contains 333 amino acids. Both p52 and p75 have strong interactions with the VP16 activation domain and with various components of the general transcriptional machinery. p52 is the more active transcription activator and has also been shown to recruit the pre-mRNA splicing factor ASF/SF to sites of active transcription. Interestingly, p52/p75 has also been identified as Lens Epithelium-Derived Growth Factor (LEDGF). In serum free media, LEDGF stimulates the growth and survival of a variety of cells, such as lens epithelial cells, retinal photoreceptor cells, COS7 cells, skin fibroblasts, and keratinocytes. In retinal photoreceptor cells, LEDGF is found in the nucleus where it promotes resistance to serum starvation and thermal stress. Thus, the LEDGF gene encodes splice variants that may regulate gene transcription and mRNA splicing of a variety of proteins that are essential for cell growth and survival.
Development References (5)
-
Cherepanov P, Maertens G, Proost P. HIV-1 integrase forms stable tetramers and associates with LEDGF/p75 protein in human cells. J Biol Chem. 2003; 278(1):372-381. (Biology: Gel shift, Immunofluorescence, Immunoprecipitation, Western blot). View Reference
-
Ge H, Si Y, Roeder RG. Isolation of cDNAs encoding novel transcription coactivators p52 and p75 reveals an alternate regulatory mechanism of transcriptional activation. EMBO J. 1998; 17(22):6723-6739. (Biology). View Reference
-
Ge H, Si Y, Wolffe AP. A novel transcriptional coactivator, p52, functionally interacts with the essential splicing factor ASF/SF2. Mol Cell. 1998; 2(6):751-759. (Biology). View Reference
-
Nakamura M, Singh DP, Kubo E, Chylack LT Jr, Shinohara T. LEDGF: survival of embryonic chick retinal photoreceptor cells. Invest Ophthalmol Vis Sci. 2000; 41(5):1168-1175. (Biology). View Reference
-
Singh DP, Kimura A, Chylack LT Jr, Shinohara T. Lens epithelium-derived growth factor (LEDGF/p75) and p52 are derived from a single gene by alternative splicing. Gene. 2000; 242(1-2):265-273. (Biology). View Reference
Please refer to Support Documents for Quality Certificates
Global - Refer to manufacturer's instructions for use and related User Manuals and Technical data sheets before using this products as described
Comparisons, where applicable, are made against older BD Technology, manual methods or are general performance claims. Comparisons are not made against non-BD technologies, unless otherwise noted.
For Research Use Only. Not for use in diagnostic or therapeutic procedures.